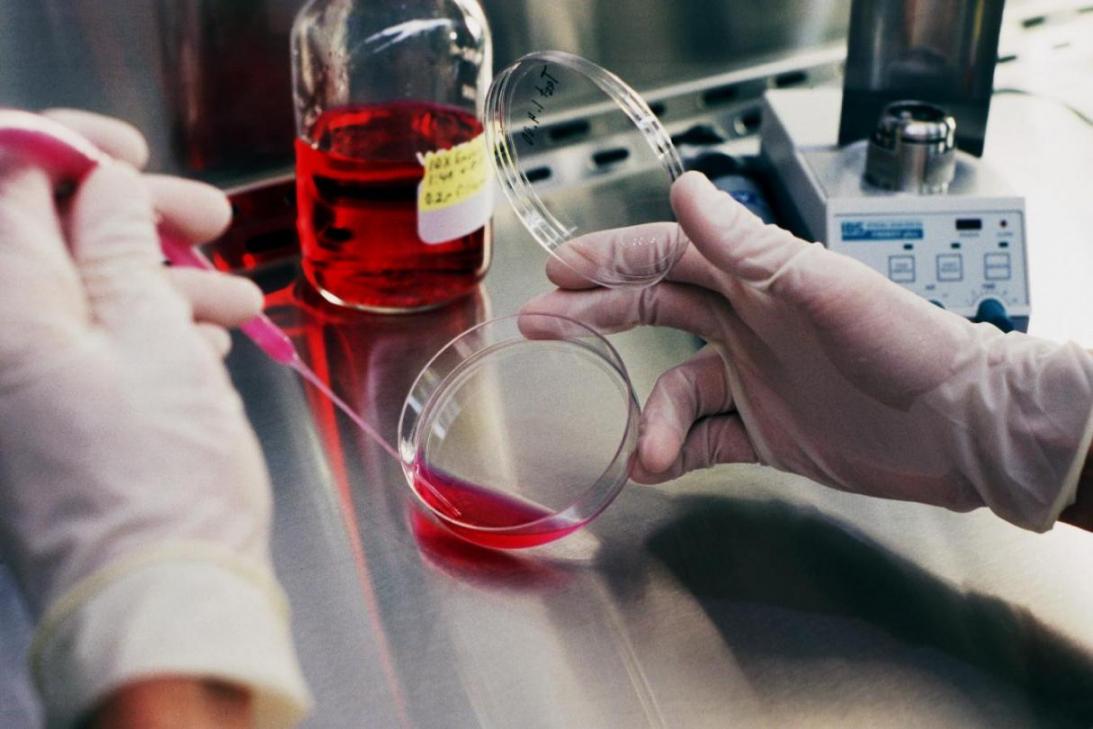

As an interdisciplinary subject, biotechnology provides the ground for commercialization to which professionals and graduates of all disciplines can contribute to, Mehr news agency reported this week, citing Vice President for Science and Technology Sorena Sattari.
Speaking at a press conference on the sidelines of the third biotechnology festival held in Tehran, the official said biotechnology is considered among the highest level businesses and “notable efforts have been made during the past year to develop it.”
Some companies have even started to export their products, he said. “As one of the four main scientific spheres, biotechnology will undoubtedly have a bright future in Iran.”
Sattari then spoke of government efforts to help elevate the quality of academic research and projects. Stressing that the research projects have considerably increased in number he admitted that the quality is yet to improve. “To become a leading scientific country, a broader and stronger presence at the international level is a must and to do this the science and technology office of the president has set up a program to effectively draw on the scientific potential of the country,” he added.
Sattari said steps have already been taken to help researchers and academics publish their papers in international journals. The next step is to create a special society for academia that would help researchers exchange views and discuss latest scientific findings.